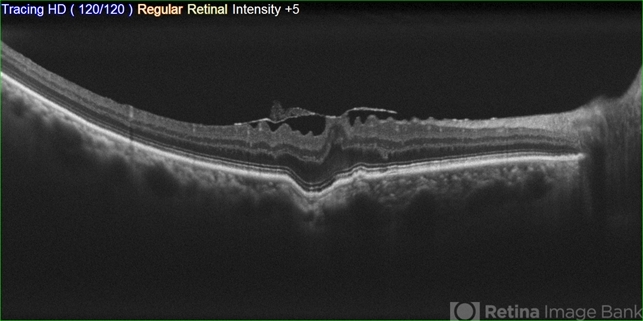

File number: 30100
Comments
-
Andre Beckenkamp (April 23 2021)
Focal choroidal excavation and Epiretinal membrane
Sign in to comment.
-
By Andre Beckenkamp
UPO - Uploaded on Jun 27, 2019.
- Last modified by Jennifer Carstens on Nov 23, 2021.
- Rating
- Appears in
- Miscellaneous
- Condition/keywords
- choroidal excavation, epiretinal membrane (ERM)
- Photographer
- Andre Beckenkamp
- Imaging device
-
Optical coherence tomography system
Nidek RS 3000 - Description
- 56 y.o. male complaining of blurred vision.